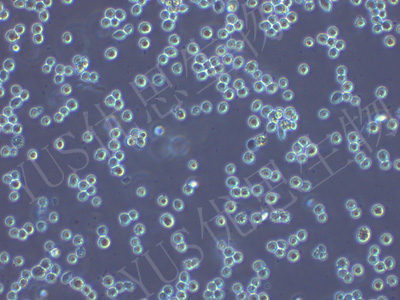

产品中心
产品中心
-

huh-7.5.1 人肝癌细胞(STR鉴定)
货号:YLH382规格: 1*10^6 -
CEM/C1 人急性淋巴细胞白血病细胞(STR鉴定)
货号:YLH383规格: 1*10^6 -

HFL1 人胚肺成纤维细胞(STR鉴定)
货号:YLH384规格: 1*10^6 -

NCI-H2126 人肺癌细胞(STR鉴定)
货号:YLH385规格: 1*10^6 -

C8166 人T淋巴细胞白血病细胞(STR鉴定)
货号:YLH386规格: 1*10^6 -

COV434 人卵巢颗粒肿瘤细胞(STR鉴定)
货号:YLH387规格: 1*10^6 -

2V6.11 人胚肾细胞(STR鉴定)
货号:YLH388规格: 1*10^6 -

Caco-2 人结直肠腺癌细胞(STR鉴定)
货号:YLH389规格: 1*10^6 -

HTR-8/Svneo 人胚胎滋养细胞(STR鉴定)
货号:YLH391规格: 1*10^6 -

MOLT-4 人急性淋巴母细胞性白血病细胞(STR鉴定)
货号:YLH392规格: 1*10^6 -

NCI-H295R 人肾上腺皮质腺癌细胞(STR鉴定)
货号:YLH393规格: 1*10^6 -

HCC1833 人肺癌腺癌细胞(STR鉴定)
货号:YLH395规格: 1*10^6
在线咨询
Online consultation

关注微信公众号


